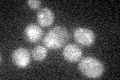
YMR162C
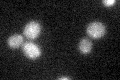
YMR162C

View description
Aminophospholipid translocase (flippase) that maintains membrane lipid asymmetry in post-Golgi secretory vesicles; localizes to the trans-Golgi network; likely involved in protein transport; type 4 P-type ATPase
Localization:
Intensity:
Fold change:
Significance:
-
C’ GFP library in SD
below threshold18.68 -
N' NOP1pr-GFP in SD

ER40.511 -
N' TEF2pr-mCherry in SD

ER,vacuole34.3141 -
N' NATIVEpr-GFP in SD

below threshold18.0129 -
N' TEF2pr-VC and Cyto-VN in SD

below threshold29.232 -
C’ GFP library in SD+DTT

cytosol22.441.2No -
C’ GFP library in SD+H2O2
cytosol22.81.22No -
C’ GFP library in Starvation Media

cytosol20.591.1No -
C’ GFP library on the background of Pup2-DaMP

below threshold -
C’ GFP library on the background of CCT mutant

below threshold17.05440.912578No
